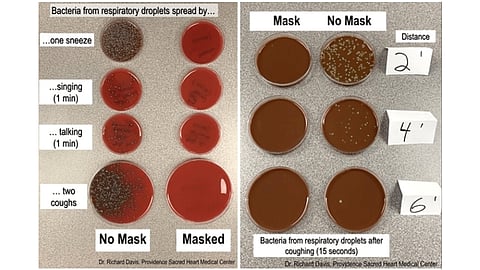
your mask Does prevent Virus? Which Type of mask Prevent virus

पुणे : कोरोनाचा संसर्ग रोखण्यासाठी तोंडाला लावलेला मास्क खरंच किती उपयोगी आहे. याबद्दल बहुतेकांच्या मनात शंका असेल. तसेच तो शास्त्रीय पद्धतीने कसा वापरायचा, असा प्रश्नही तुम्हाला पडला असेल. वॉशिंग्टन येथील सुक्ष्मजीवशास्त्रज्ञ डॉ. रिचर्ड डेव्हिस यांनी प्रत्यक्ष नमुने घेऊन प्रयोगशाळेत सुक्ष्मदर्शकाखाली तपासले आहे. त्यामध्ये तोंड आणि नाकातून बाहेर पडणाऱ्या द्रवाला "मास्क' 100 टक्के रोखत असल्याचे सिद्ध झाले आहे.
पुण्याच्या बातम्या वाचण्यासाठी येथे क्लिक करा
भारतातही संख्याशास्त्राच्या आधारावर मास्क उपयोगी असल्याचे सांगितले होते. पण प्रत्यक्ष नमुन्यांच्या चाचणीमुळे "हा सूर्य आणि हा जयद्रथ' इतकं स्पष्टपणे मास्कचा उपयोग असल्याचे सिद्ध झाले आहे. डेव्हिस यांनी शिंका आल्यावर, बोलल्यावर, गायन केल्यावर आणि खोकल्यानंतर मास्क घातलेला असताना आणि नसतानाही बाहेर पडणाऱ्या नमुन्यांची चाचणी केली आहे. त्यामध्ये स्पष्टपणे जीवाणूंच्या झालेल्या वाढीतून हा फरक दिसून येतो. तसेच अंतर वाढवूनही त्यांनी हा प्रयोग केला आहे. सर्व नमुन्यांच्या चाचणीतून मास्क घालणे सगळ्यात फायदेशीर असल्याचे लक्षात आले आहे.
----------------
जिओमध्ये आणखी एक मोठी गुंतवणूक; आता कोणी केली गुंतवणूक?
----------------
चांगली बातमी : भारतात कोरोनावरील दुसरी लसही विकसित
----------------
मास्कचा चुकीचा वापर ठरेल घातक ः
पोलिसांची भीती किंवा जनाची लाज म्हणून बाहेर पडल्यावर मास्क घालणारे अनेक लोक दिसतात. परंतु तो मास्क योग्य पद्धतीने घातलाय का? त्यातून संसर्ग तर होणार नाही ना? याची काळजी मात्र कोणीही घेताना दिसत नाही.
मास्क कसा असावा?
- वैद्यकीय कर्मचारी वगळता इतरांनी मास्क घेताना त्याचे कापड, आकार आणि श्वसनासाठीची योग्यता तपासणे गरजेचे.
- शक्यतो सुती कपड्याचा तोंड आणि नाक व्यवस्थित झाकणारा मास्क निवडावा.
- दोन किंवा अधिक पडदे असलेला आणि नाका जवळ फुगवटा असलेला मास्क उत्तम.
- मास्कच्या कडा चेहऱ्यावर व्यवस्थित "फिट्ट' झाल्या पाहिजे.
- वॉल्व असलेला मास्क शक्यतो टाळा.
मास्क लावताना ही घ्या काळजी?
- मास्क हातात घेण्यापूर्वी आणि काढण्यापूर्वी हात साबणाने स्वच्छ धुवा.
- तुटलेला, खराब असलेला मास्क वापरू नका.
- मास्कच्या दोन्ही बाजूंच्या दोऱ्यांनाच हात लावा.
- नाक, तोंड आणि हनूवटी झाकेल, तसेच कुठेही गॅप राहणार नाही अशा पद्धतीने मास्क बांधा.
- स्वच्छ प्लास्टिक किंवा इतर बॅगमध्ये मास्क ठेवा.
- मास्क नियमित स्वच्छ धुवा.
हे टाळाच ः
- सैल असलेला मास्क वापरू नका.
- नाक उघडे ठेवू नका.
- श्वास घ्यायला अडचण येत असलेले मास्क वापरू नका.
- आपला मास्क दुसऱ्याला देऊ नका.
- ओले, अस्वच्छ, प्लास्टिक पासून बनलेले, कमी आकाराचे मास्क वापरू नका.
- सतत मास्कला हात लावू नका.
- बोलताना मास्क काढू नका.
- चुकीच्या पद्धतीने दुसरी व्यक्ती जवळ असताना मास्क काढू नका.
सकाळ+ चे सदस्य व्हा
ब्रेक घ्या, डोकं चालवा, कोडे सोडवा!
शॉपिंगसाठी 'सकाळ प्राईम डील्स'च्या भन्नाट ऑफर्स पाहण्यासाठी क्लिक करा.
Read latest Marathi news, Watch Live Streaming on Esakal and Maharashtra News. Breaking news from India, Pune, Mumbai. Get the Politics, Entertainment, Sports, Lifestyle, Jobs, and Education updates, मराठी ताज्या बातम्या, मराठी ब्रेकिंग न्यूज, मराठी ताज्या घडामोडी. And Live taja batmya on Esakal Mobile App. Download the Esakal Marathi news Channel app for Android and IOS.